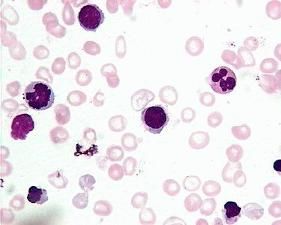
意向障礙

病因
1.生物學因素:研究發現此類病人的腦電圖異常多見,特別是顳葉的腦電波異常明顯。
2.心理學因素:意向障礙有相同的緊張源——力必多和攻擊本能驅使以及抵抗它們的自我防禦機制的間歇性失效,患者在其他方面往往具有正常功能,Fenichel(1945)則認為此類患者的行為意義並不在於得到快感,而是在於解除痛苦,患者試圖通過這類行為使自己從焦慮、內疚、抑鬱和其他內心痛苦中解脫出來,以獲得輕鬆感,可使緊張狀態得以暫時解除,雖然行為的破壞性後果將帶來更多的痛苦(法律制裁),但由於前者具有近期效應,使得患者不計後果,一再重蹈復轍。
3.酒精和藥物濫用:可出現中樞神經系統的病理性損害,出現腦功能障礙,自我克制功能減弱,出現偷竊、縱火等行為。
4.精神疾病:精神發育遲滯、精神分裂症、強迫性神經症等均可出現類似行為。
臨床表現
意向障礙1.病理性賭博:通常在青春早期開始賭博活動,男性多於女性, 意向障礙(精神發育遲緩)可見於各個種族、社會階層和職業,但以受教育程度低者為多。其心理特徵為智力較高、傲慢、過於自信、極其樂觀好動,缺乏耐心等,關於病理性賭博,一般認為參與賭博的時間或輸掉錢財的多少並不十分重要,重要的是賭博行為對賭場以外的人際關係有嚴重影響,對賭博者個人和家庭生活有長期的、日益加劇的損害,經常由於賭博而不能所履行承擔的社會和工作職責。個人渴望賭博,完全沉溺於賭博之中而對生活中的其他事物置之不理,需要增加賭博次數或賭注數目以獲得所追求的興奮。
2.縱火狂:反覆出現的不可克制的縱火衝動,對縱火行為和火焰燃燒的場面有強烈的迷戀、興趣和好奇心。縱火前有強烈的緊張感,縱火或目擊火焰時有明顯的愉快、滿足或輕鬆的體驗。縱火者缺乏動機,不是為了得到錢財,也不是為了掩蓋罪行或表達某種社會政治觀點,不是出於憤怒的報復,儘管縱火是由於不可克制的衝動所致,但事先可有計畫和準備。
心理學研究認為,縱火衝動是一種無意識的性行為的象徵,縱火狂有一種強烈的施虐淫慾望,火的破壞力量可視為強烈性慾的象徵。另有人認為縱火衝動源於攻擊本能,yarnell(1940)認為兒童縱火是對排斥過他們的家庭成員的一種攻擊形式,這些人常伴有逃學、偷竊、離家出走等現象。
3.偷竊狂:主要特徵為反覆出現的不可克制的偷竊衝動。其偷竊行為即不是由於當時生活需要,也不是考慮偷竊物的經濟價值。偷竊即不是為了泄怒,也不是為了報復。行竊之前或緊接行竊之後有逐漸加重的緊張感,行竊後有愉快和放鬆的體驗。偷竊即無長遠的計畫,也不與他人合夥進行。他們將偷竊物品棄之或偷偷放回原處,或將其隱藏。過後他們常因想像中的或已經發生的被捕以及社會地位的喪失而感抑鬱焦慮和內疚。偷竊狂常始於童年或青少年時期,病程上具有慢性傾向,自發緩慢率不詳,但較少持續至中年。由於疾病對個的社交與工作能力並無損害,很少主動求治。
4.異食癖:是一種食慾倒錯現象,嗜食一些通常不能作為食物的東西,如泥土、磚頭、碎玻璃等。經常異食可引起全身營養不良或發生食物中毒。
5.拔牙癖:指反覆出現的、不可克制的拔牙行為。多見於兒童,病因不明,常有頭髮稀疏和頭部皮膚感染。
鑑別診斷
一、病理性賭博
意向障礙(一)賭博指昌輸贏錢財之危險,而有意識地進行某種部分地或全部由機會決定其結局的遊戲或類似遊戲的活動。普通賭博與病理性賭博很難截然分開,有人認為病理性賭博實質上是賭博行為的成癮,正如普通飲酒與酒精成癮一樣。
(二)精神疾病伴發的賭博行為精神疾病如精神分裂症、躁狂症等可能有賭博行為,但其賭博行為的出現多有精神病理基礎,如精神分裂症可在幻覺或妄想的支配下,出現賭博行為,躁狂症可在其情緒高漲、自高自傲、自命不凡的基礎上出現明顯的賭博行為。精神疾病伴發的賭博行為除此外,還有相應的其他精神病理現象,如感知、思維障礙等。
(三)精神活性物質濫用伴發的賭博行為精神活性物質濫用如酒精、毒品可以出現賭博行為,多由於本身控制能力減弱及相應的經濟原因,而懷著僥倖贏錢的心理,以便購得其使用精神活性物質而賭博,此類病人有明顯漫長的精神活性物質濫用史及相應的軀體體徵,可以明確診斷。
二、縱火狂
(一)犯罪縱火此類縱火有明確的報復動機及周密的縱火計畫和逃避罪行的行為。
(二)精神疾病的縱火行為此類患者的縱火行為多有明確的精神病理現象,縱火多在幻覺或妄想的支配下出現,多無明確的動機和行為計畫,亦無相應的逃避行為。除縱火行為外,還有其他的精神症狀。
(三)精神發育遲緩由於其智慧型的缺損,對自己行為不能控制或對其行為後果不能辨認,而出現縱火行為,此類患者智慧型測查後即可明確診斷。
三、偷竊狂
(一)偷竊偷竊多以生活需要為目的,偷竊物多有明確實用價值及經濟價值,偷竊後有明顯的逃避行為,常多結伴行竊。
(二)精神疾病伴發偷竊行為精神分裂症、躁狂症等可伴發偷竊行為,此行為外尚有其他的精神症狀,如感知、思維障礙等。
(三)精神發育遲緩此類患者的偷竊行為主要是認識缺損,對其行為的後果不能認識,智慧型測查即可明確診斷。
四、異食癖
(一)精神分裂症青春型患者可以出現異食行為,此外還有其他行為障礙和感知思維障礙,如幻覺、思維破裂等。
(二)精神發育遲緩可出現異食行為,見於較嚴重的患者,智慧型測查可診斷。
(三)腸道寄生蟲感染可出現異食行為,多見於兒童, 大便檢索即可明確診斷。
(四)缺鐵性貧血多見於兒童,常與腸道寄生蟲感染並發。此類患者有明顯的貧血面容,外周血象檢查:紅細胞平均體積<80立方微米,紅細胞平均血紅蛋白量<28微微克,紅細胞平均血紅蛋白濃度<300g/l。血清鐵低於50ug/dl,血清總鐵結合力可高達400-500ug/dl。
五、拔髮癖
(一)精神分裂症此類患者可出現拔髮行為,多是受幻覺妄想支配。精神檢查還可發現其他感知、思維及行為障礙。
(二)精神發育遲緩此類患者可以出現拔髮行為,多是由於其認識功能缺損而自控能力喪失。智慧型測查可明確診斷。